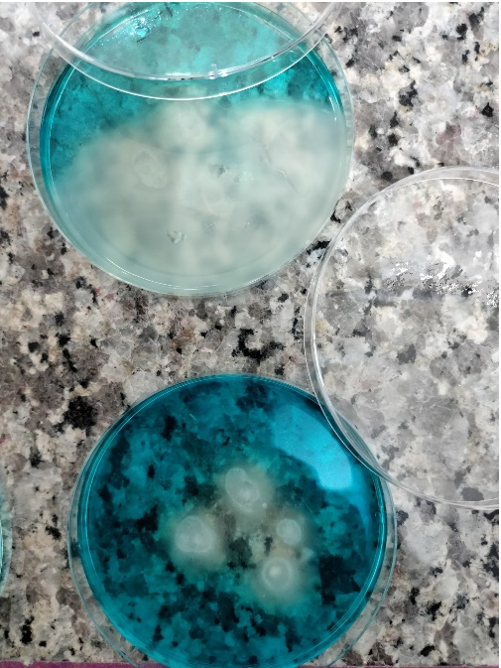
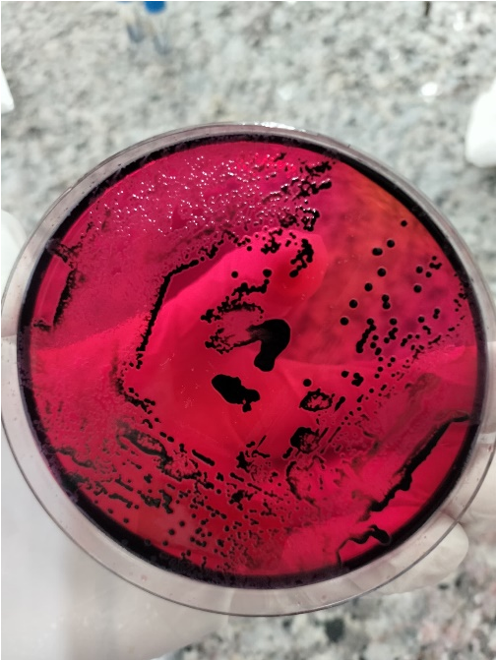

In ODIN Work Package 2, the wastewater and environmental sampling campaign ran from January to September 2025 across Tanzania, Burkina Faso, and the Democratic Republic of the Congo (DRC). Samples were collected monthly from predetermined locations (see ODIN WP2 D2.2 R eport: Protocol for Environmental Pathogen Surveillance in Sub-Saharan Countries). The number of sampling locations varied by month and country.
|
Country |
Number of Sampling Locations |
||
|
Wastewater |
Surface Water |
Drinking Water |
|
|
Dar es Salaam, Tanzania |
5 |
1 |
7 |
|
Tanga, Tanzania |
1 |
1 |
2 |
|
Ouagadougou, Burkina Faso |
7 |
2 |
2 |
|
Nanoro, Burkina Faso |
1 |
1 |
2 |
|
Kinshasa, DRC |
5 |
2 |
5 |
The samples were collected from wastewater, surface water, and drinking water (groundwater and tap water) sources across five cities in sub-Saharan Africa. Fecal indicator bacteria (Escherichia coli and intestinal enterococci) and priority pathogens—Vibrio cholerae, Salmonella Typhi, extended-spectrum beta-lactamase (ESBL)–producing Escherichia coli and Klebsiella pneumoniae, and carbapenemase-producing Enterobacteriaceae (CPE) Escherichia coli and Klebsiella pneumoniae—were analyzed using culture-based microbiological methods in local laboratories.
Work Package 2 is currently compiling the analysis results. Whole Genome Sequencing (WGS) of the isolated bacterial strains is underway. The quantified levels of priority pathogens will support the quantitative microbial risk assessment (QMRA) studies being conducted under ODIN Work Package 5.
This content was prepared by Kristiina Valkama, Finnish Institute for Health and Welfare (THL) in collaboration with the ODIN Wastewater Surveillance Project Work Package 2 led by Tarja Pitkänen.
Also By
- ODIN Illumina training at the Clinical Research Unit of Nanoro, Nanoro, Burkina Faso
- Formation à l'utilisation du système ODIN Illumina à l'Unité de recherche clinique de Nanoro, Nanoro, Burkina Faso
- Promouvoir l'accès à l'eau potable grâce aux plans de sécurité sanitaire [PL1.1]de l'eau (WSP) et aux plans de sécurité sanitaire de l'assainissement (SSP) en Afrique subsaharienne

Please Sign in (or Register) to view further.